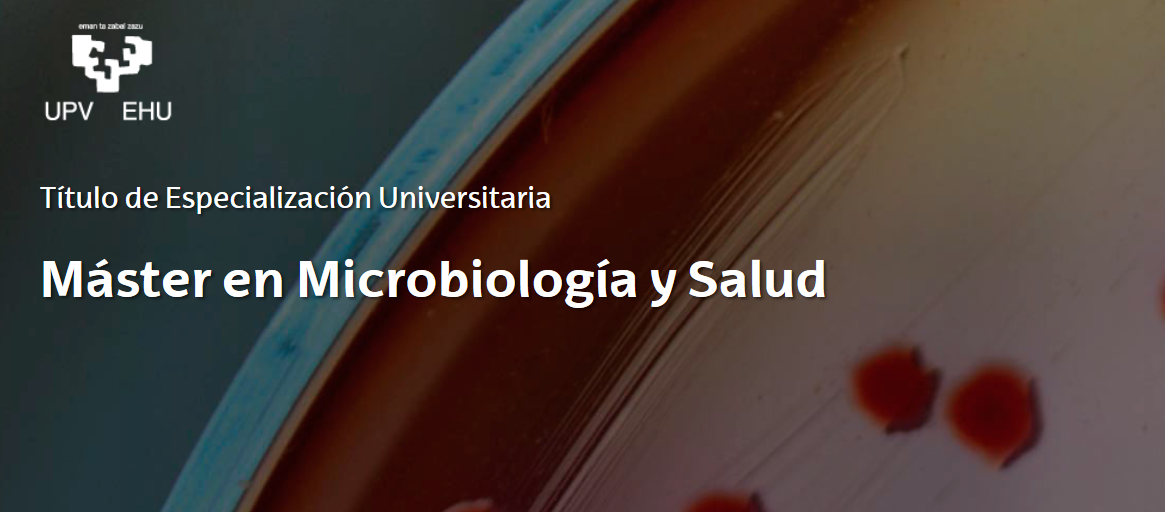

Máster en Microbiología y Salud
La Microbiología es hoy una disciplina común y básica en todos los campos de especialización relacionados con las Ciencias Biosanitarias y Biomédicas, ya que el papel de los microorganismos es muy importante tanto en el ámbito sanitario, como en el de los ecosistemas y el alimentario. La trascendencia de la microbiología es innegable en la lucha contra enfermedades pandémicas como el sida, el paludismo o la tuberculosis, principales causas de mortalidad en muchos países a nivel mundial. Igual importancia alberga desde el punto de vista de los alimentos como vehículo de infecciones, y de las características prebióticas que ciertos microorganismos confieren a ciertos alimentos. Medioambientalmente, los microorganismos son los principales encargados de mantener el ciclo biogeoquímico en los ecosistemas y su influencia en la salud.
En este contexto, el máster en Microbiología y Salud tiene como objetivo dotar al alumnado de de formación avanzada en microbiología y en áreas relacionadas, como la parasitología y la inmunología, tanto a nivel de adquisición de conocimientos sobre los microorganismos y habilidades de laboratorio, como de herramientas metodológicas para afrontar una investigación en microbiología.
El programa formativo otorga los conocimientos teóricos y prácticos necesarios en el desarrollo en contextos multidisciplinares de los procedimientos de laboratorio, experimentales y de bioseguridad, para estudiar el papel de los microorganismos en la salud y el medio ambiente.
Este máster está orientado hacia la actividad investigadora y da acceso directo al Programa de Doctorado en Inmunología, Microbiología y Parasitología.
El grupo de investigación de participa en la docencia de este Máster en las siguientes asignaturas: